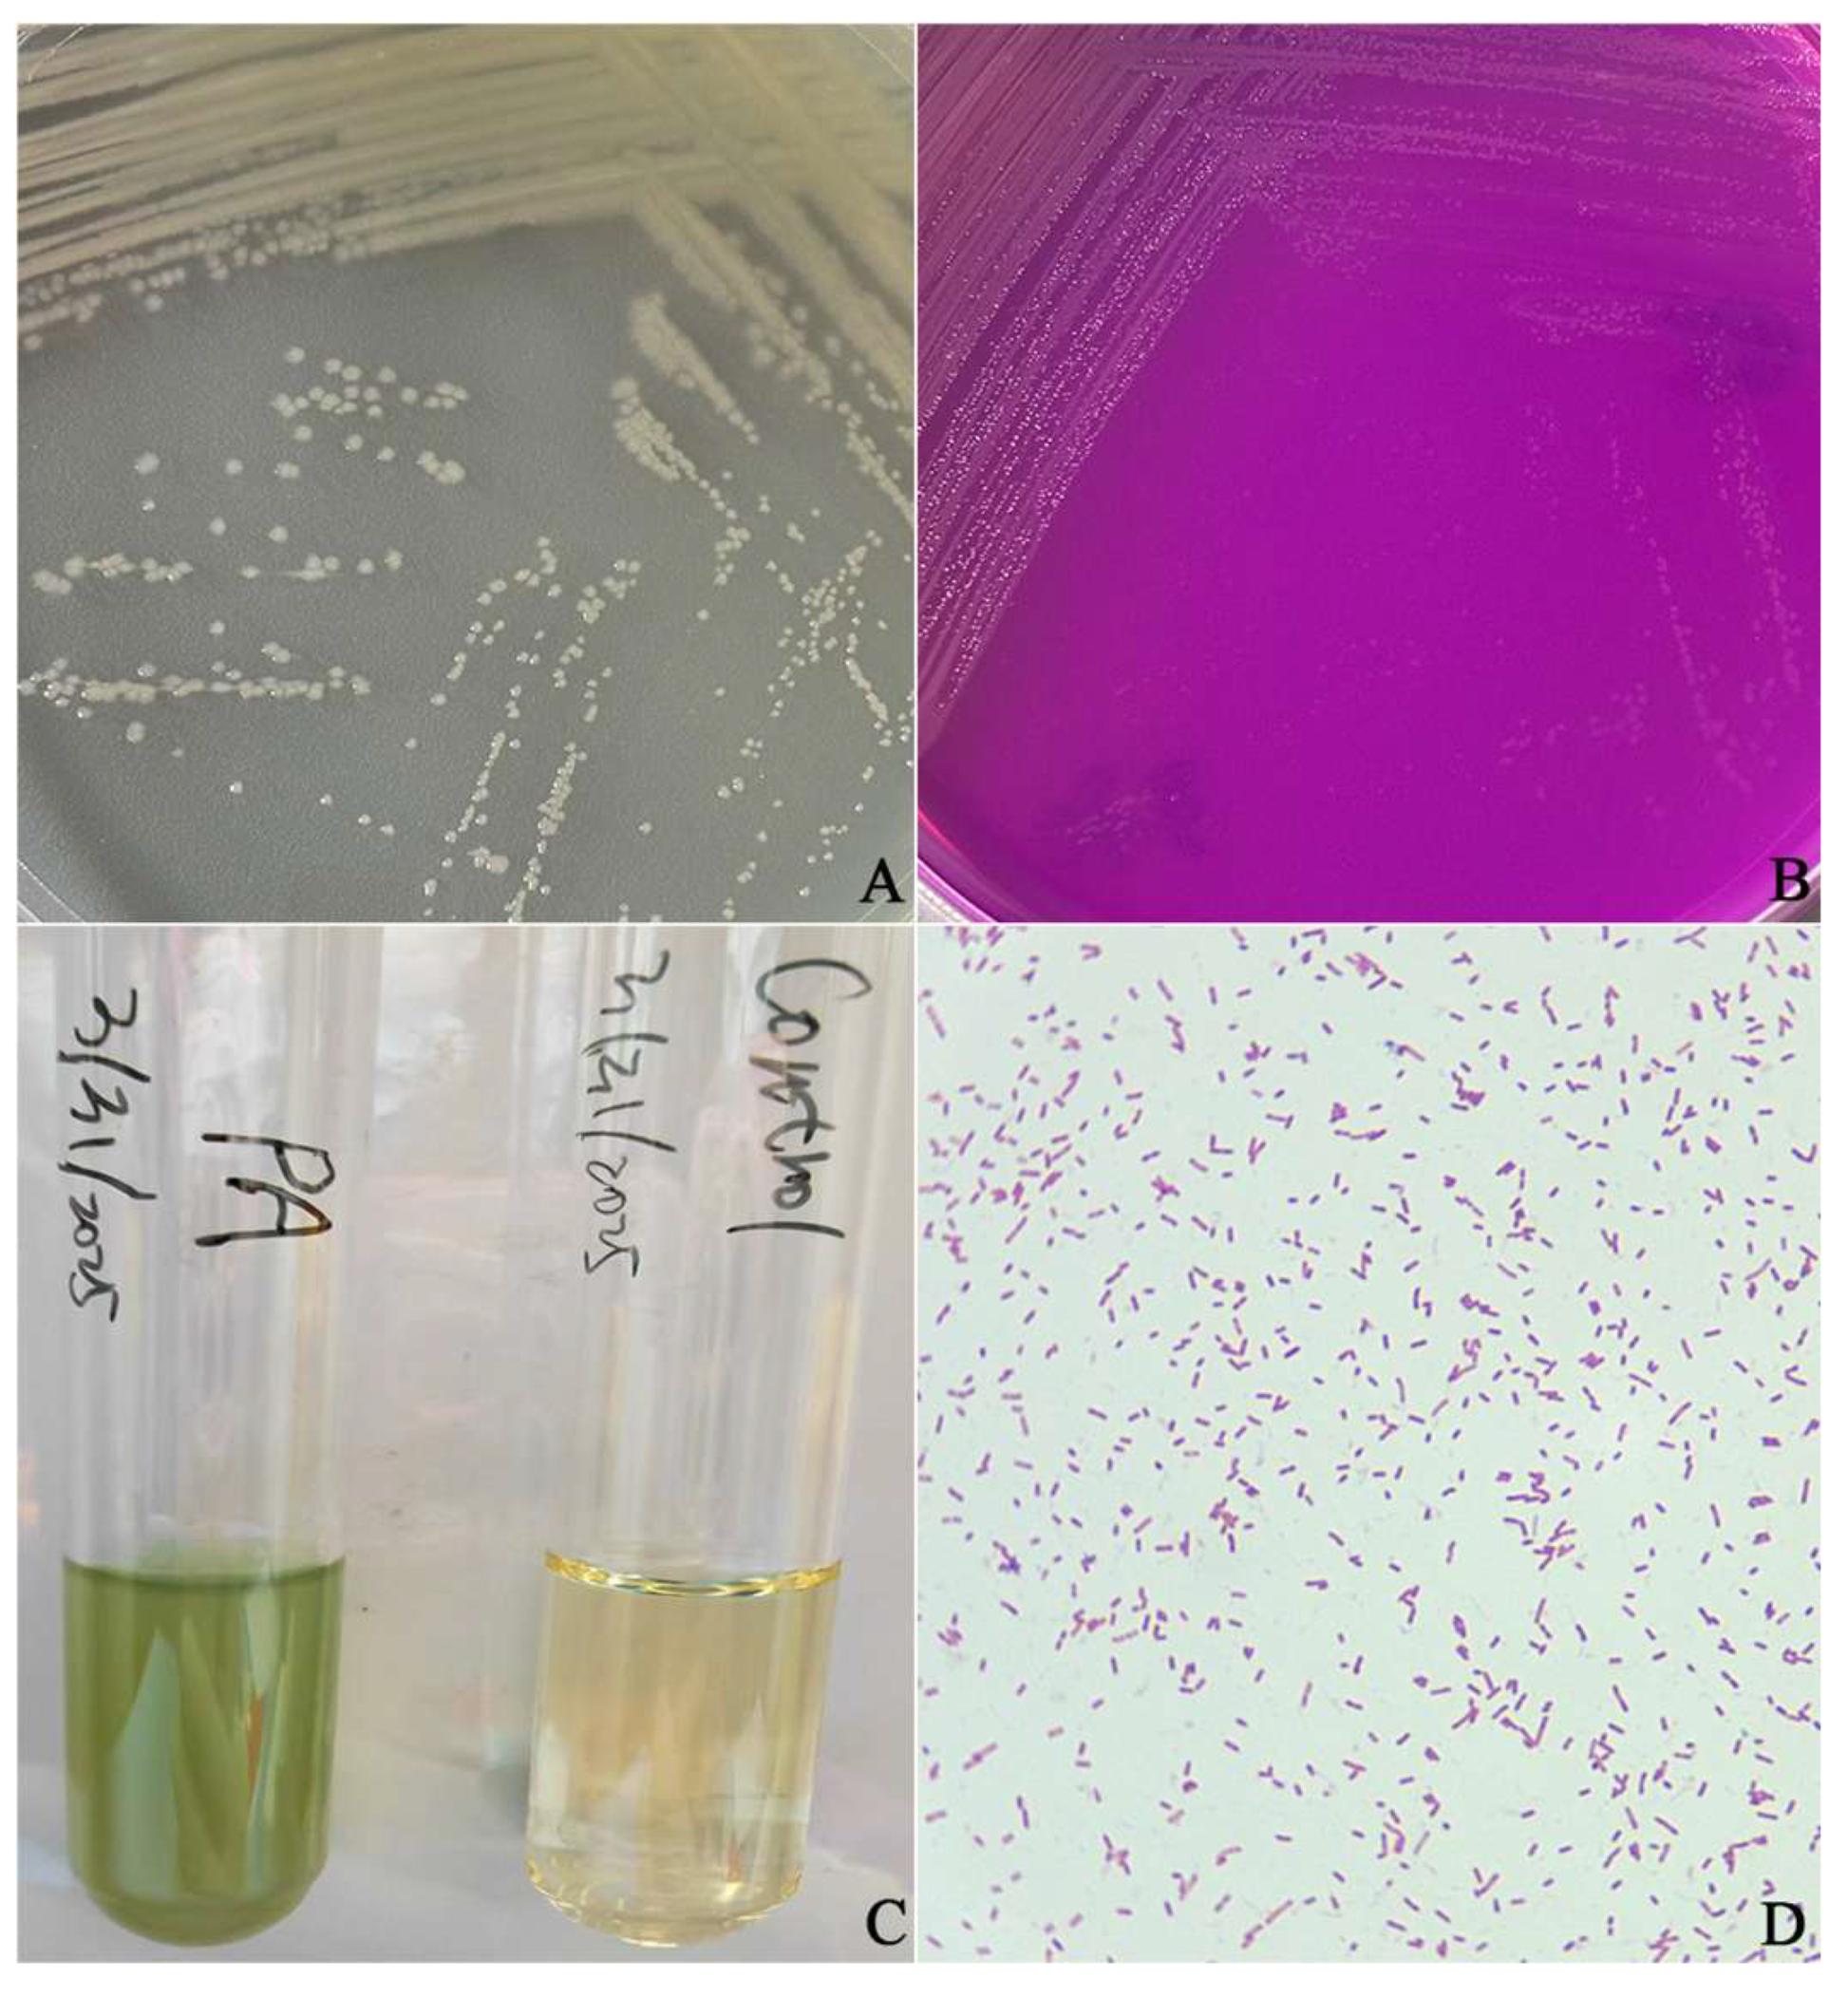
Vetsci 12 00636 g001

Isolation, Identification, and Drug Sensitivity Test of Pseudomonas aeruginosa from Cynomolgus Monkey (Macaca fascicularis)
Simple Summary
Abstract
1. Introduction
2. Materials and Methods
2.1. Samples
2.2. Bacterial Isolation and Morphological Observation
2.3. Physiological and Biochemical Identification
2.4. Bacterial 16S rRNA Amplification and Sequencing
2.5. Sequence Alignment Analysis and Construction of Phylogenetic Tree
2.6. Antibiotic Susceptibility Testing
2.7. Bacterial Artificial Regression Infection Test
3. Results
3.1. Morphological Characteristics of Bacteria
3.2. Results of Bacterial Biochemical Identification
3.3. 16S rRNA Gene Sequencing, Homology Comparison, and Phylogenetic Analysis
3.4. Antimicrobial Susceptibility Test Results of the Isolated Strain
3.5. Results of Animal Pathogenicity Tests
4. Discussion
5. Conclusions
Supplementary Materials
Author Contributions
Funding
Institutional Review Board Statement
Informed Consent Statement
Data Availability Statement
Conflicts of Interest
References
- Belmonte, J.C.I.; Callaway, E.M.; Churchland, P.; Caddick, S.J.; Feng, G.; Homanics, G.E.; Lee, K.F.; Leopold, D.A.; Miller, C.T.; Mitchell, J.F.; et al. Brains, Genes, and Primates. Neuron 2015, 86, 617–631. [Google Scholar] [CrossRef] [PubMed]
- Li, H.L.; Chen, Z.G.; Ning, Q.; Zong, F.L.; Wang, H. Isolation and Identification of Morganella morganii from Rhesus Monkey (Macaca mulatta) in China. Vet. Sci. 2024, 11, 223. [Google Scholar] [CrossRef] [PubMed]
- Maaskant, A.; Voermans, B.; Levin, E.; de Goffau, M.C.; Plomp, N.; Schuren, F.; Remarque, E.J.; Smits, A.; Langermans, J.A.M.; Bakker, J.; et al. Microbiome signature suggestive of lactose-intolerance in rhesus macaques (Macaca mulatta) with intermittent chronic diarrhea. Anim. Microbiome 2024, 6, 53. [Google Scholar] [CrossRef]
- Maaskant, A.; Blees, N.R.; Smits, A.; Corbee, R.J.; Bakker, J.; Langermans, J.A.M.; Remarque, E.J. Evaluation of commercial diets on fecal consistency and defecation frequency in rhesus macaques (Macaca mulatta) with chronic intermittent idiopathic diarrhea. Lab. Anim. Res. 2025, 41, 15. [Google Scholar] [CrossRef]
- Keita, M.B.; Hamad, I.; Bittar, F. Looking in apes as a source of human pathogens. Microb Pathog. 2014, 77, 149–154. [Google Scholar] [CrossRef]
- Rhoades, N.; Barr, T.; Hendrickson, S.; Prongay, K.; Haertel, A.; Gill, L.; Garzel, L.; Whiteson, K.; Slifka, M. Maturation of the infant rhesus macaque gut microbiome and its role in the development of diarrheal disease. Genome Biol. 2019, 20, 173. [Google Scholar] [CrossRef]
- Palleroni, N.J. The Pseudomonas Story. Environ. Microbiol. 2010, 12, 1377–1383. [Google Scholar] [CrossRef]
- Fred, C.; Nicolau, D.P.; Gill, C.M. Carbapenemaseproducing Pseudomonas aeruginosa—An emerging challenge. Emerg. Microbes Infect. 2022, 11, 811–814. [Google Scholar]
- Chung, J.; Eisha, S.; Park, S.; Morris, A.J.; Martin, I. How three self-secreted biofilm exopolysaccharides of Pseudomonas aeruginosa, psl, pel, and alginate, can each be exploited for antibiotic adjuvant effects in cystic fibrosis lung infection. Int. J. Mol. Sci. 2023, 24, 8709. [Google Scholar] [CrossRef]
- Huang, Y.; Bai, L.; Yang, Y.T.; Yin, Z.H.; Guo, B.L. Biodegradable gelatin/silver nanoparticle composite cryogel with excellent antibacterial and antibiofilm activity and hemostasis for Pseudomonas aeruginosa-infected burn wound healing. J. Colloid Interface Sci. 2022, 608, 2278–2289. [Google Scholar] [CrossRef]
- Thuenauer, R.; Landi, A.; Trefzer, A.; Altmann, S.; Wehrum, S.; Eierhoff, T.; Diedrich, B.; Dengjel, J.; Nyström, A.; Imberty, A.; et al. The Pseudomonas aeruginosa lectin LecB causes integrin internalization and inhibits epithelial wound healing. mBio 2020, 11, e03260-19. [Google Scholar] [CrossRef] [PubMed]
- Khan, M.; Stapleton, F.; Summers, S.; Rice, S.A.; Willcox, M.D.P. Antibiotic resistance characteristics of Pseudomonas aeruginosa isolated from keratitis in Australia and India. Antibiotics 2020, 9, 600. [Google Scholar] [CrossRef] [PubMed]
- Bisht, K.; Baishya, J.; Wakeman, C.A. Pseudomonas aeruginosa polymicrobial interactions during lung infection. Curr. Opin. Microbiol. 2020, 53, 1–8. [Google Scholar] [CrossRef] [PubMed]
- Martínez-Alemán, S.; Bustamante, A.E.; Jimenez-Valdes, R.J.; González, G.M.; Sánchez-González, A. Pseudomonas aeruginosa isolates from cystic fibrosis patients induce neutrophil extracellular traps with different morphologies that could correlate with their disease severity. Int. J. Med. Microbiol. 2020, 310, 151451. [Google Scholar] [CrossRef]
- Plebani, R.; Potla, R.; Soong, M.; Bai, H.Q.; Izadifar, Z.; Jiang, A.; Travis, R.N.; Belgur, C.; Dinis, A.; Cartwright, M.J.; et al. Modeling pulmonary cystic fibrosis in a human lung airway-on-a-chip. J. Cyst. Fibros. 2022, 21, 606–615. [Google Scholar] [CrossRef]
- Gajdács, M. Carbapenem-Resistant but Cephalosporin-Susceptible Pseudomonas aeruginosa in Urinary Tract Infections: Opportunity for Colistin Sparing. Antibiotics 2020, 9, 153. [Google Scholar] [CrossRef]
- McVey, M.J.; Maishan, M.; Foley, A.; Turki, R.; Roach, E.J.; Deschler, R.; Weidenfeld, S.; Goldenberg, N.M.; Khursigara, C.M.; Kuebler, W.M. Pseudomonas aeruginosa membrane vesicles cause endothelial barrier failure and lung injury. Eur. Respir. J. 2022, 59, 2101500. [Google Scholar] [CrossRef]
- Chalmers, J.D.; Polverino, E.; Crichton, M.L.; Ringshausen, F.C.; De Soyza, A.; Vendrell, M.; Burgel, P.R.; Haworth, C.S.; Loebinger, M.R.; Dimakou, K.; et al. Bronchiectasis in Europe data on disease characteristics from the European Bronchiectasis registry (EMBARC). Lancet Respir. Med. 2023, 11, 637–649. [Google Scholar] [CrossRef]
- Holmes, C.L.; Anderson, M.T.; Mobley, H.L.T.; Bachman, M.A. Pathogenesis of Gram-Negative Bacteremia. Clin. Microbiol. Rev. 2021, 34, e00234-20. [Google Scholar] [CrossRef]
- Rodrigues, Y.C.; Furlaneto, I.P.; Maciel, A.H.P.; Quaresma, A.J.P.G.; De Matos, E.C.O.; Conceiçao, M.L.; Vieira, M.C.D.; Brabo, G.L.D.; Sarges, E.D.N.F.; Lima, L.N.G.C.; et al. High prevalence of atypical virulotype and genetically diverse background among Pseudomonas aeruginosa isolates from a referral hospital in the Brazilian Amazon. PLoS ONE 2020, 15, e0238741. [Google Scholar] [CrossRef]
- Bonnet, R.; Sampaio, J.L.M.; Labia, R.; De Champs, C.; Sirot, D.; Chanal, C.; Sirot, J. A novel CTX-M β-lactamase (CTX-M-8) in cefotaxime-resistant Enterobacteriaceae isolated in Brazil. Antimicrob. Agents Chemother. 2000, 44, 1936–1942. [Google Scholar] [CrossRef] [PubMed]
- Haenni, M.; Bour, M.; Châtre, P.; Madec, J.-Y.; Plésiat, P.; Jeannot, K. Resistance of animal strains of Pseudomonas aeruginosa to carbapenems. Front. Microbiol. 2017, 8, 1847. [Google Scholar] [CrossRef] [PubMed]
- Kelly, E.J.; Wilson, D.J. Pseudomonas aeruginosa mastitis in two goats associated with an essential oil-based teat dip. J. Vet. Diagn. Investig. 2016, 28, 760–762. [Google Scholar] [CrossRef] [PubMed]
- Darwich, L.; Seminati, C.; Burballa, A.; Nieto, A.; Durán, I.; Tarradas, N.; Molina-López, R.A. Antimicrobial susceptibility of bacterial isolates from urinary tract infections in companion animals in Spain. Vet. Rec. 2021, 188, e60. [Google Scholar] [CrossRef]
- Rubin, J.; Walker, R.D.; Blickenstaff, K.; Bodeis-Jones, S.; Zhao, S. Antimicrobial resistance and genetic characterization of fluoroquinolone resistance of Pseudomon asaeruginosa isolated from canine infections. Vet. Microbiol. 2008, 131, 164–172. [Google Scholar] [CrossRef]
- Chevalier, S.; Bouffartigues, E.; Bodilis, J.; Maillot, O.; Lesouhaitier, O.; Feuilloley, M.G.J.; Orange, N.; Dufour, A.; Cornelis, P. Structure, function and regulation of Pseudomonas aeruginosa porins. Fems. Microbiol. Rev. 2017, 41, 698–722. [Google Scholar] [CrossRef]
- Zhao, K.L.; Ma, J.N.; Wang, X.R.; Guo, Y.D.; Yue, B.S.; Chu, Y.W. Population divergence of Pseudomonas aeruginosa can lead to the coexistencewith Escherichia coli in animal suppurative lesions. Vet. Microbiol. 2019, 231, 169–176. [Google Scholar] [CrossRef]
- Zhu, Q.; Peng, H.; Li, H.; Yang, L.Z.; Zhang, B.S.; Zhu, J.; Guo, W.L.; Wang, N.; Jiang, S.J.; Xie, Z.J. Serotypes and virulence genes of Pseudomonas aeruginosa isolated from mink and its pathogenicity in mink. Microb. Pathog. 2020, 139, 103904. [Google Scholar]
- Gierløff, B. Pseudomonas aeruginosa. IV. IV. Pyocine typing of strains isolated from the blue fox (Alopex lagopus), mink (Mustela vison), and dog (Canis familiaris) and from their environment. Nord. Vet. Med. 1980, 32, 147–160. [Google Scholar]
- Cheung, A.T.; Moss, R.B.; Leong, A.B.; Novick, W.J. Chronic Pseudomonas aeruginosa endobronchitis in rhesus monkeys: I. Effects of pentoxifylline on neutrophil influx. J. Med. Primatol. 1992, 21, 357–362. [Google Scholar] [CrossRef]
- Lausen, N.C.; Richter, A.G.; Lage, A.L. Pseudomonas aeruginosa infection in squirrel monkeys. JAVMA-J. Am. Vet. Med. A 1986, 189, 1216–1218. [Google Scholar] [CrossRef]
- Stills, H.F.; Bond, M.G.; Bullock, B.C. Bacterial myocarditis in African green monkeys (Cercopithecus aethiops). Vet. Pathol. 1979, 16, 376–380. [Google Scholar] [CrossRef] [PubMed]
- Loganathan, M.; Thangavelu, R.; Pushpakanth, P.; Muthubharathi, K.; Ramesh, R.; Selvarajan, R.; Uma, S. First report of rhizome rot of banana caused by Klebsiella variicola in India. Plant Dis. 2021, 105, 2011. [Google Scholar] [CrossRef]
- Veetilvalappil, V.V.; Manuel, A.; Aranjani, J.M.; Tawale, R.; Koteshwara, A. Pathogenic arsenal of Pseudomonas aeruginosa: An update on virulence factors. Future Microbiol. 2022, 17, 465–481. [Google Scholar] [CrossRef]
- Wang, Z.W.; Tian, W.T.; Sun, S.Y.; Chen, X.; Wang, H.F. Genomic and proteomic analysis of Pseudomonas aeruginosa isolated from industrial wastewater to assess its resistance to antibiotics. Separations 2023, 10, 549. [Google Scholar] [CrossRef]
- Wamala, P.S.; Mugimba, K.K.; Mutoloki, S.; Evensen, Ø.; Mdegela, R.; Byarugaba, D.K. Occurrence and antibiotic susceptibility of fish bacteria isolated from Oreochromis niloticus (Nile tilapia) and Clarias gariepinus (African catfish) in Uganda. Fish. Aquat. Sci. 2018, 21, 6. [Google Scholar] [CrossRef]
- Quang, T.; Diem-Trang, P.; Vinhthuy, P. Using 16S rRNA gene asmarker to detect unknown bacteria in microbial communities. BMC Bioinform. 2017, 18, 499. [Google Scholar]
- Sabnis, A.; Hagart, K.L.H.; Klöckner, A.; Becce, M.; Evans, L.E.; Furniss, R.C.D.; Mavridou, D.A.I.; Murphy, R.; Stevens, M.M.; Davies, J.C.; et al. Colistin kills bacteria by targeting lipopolysaccharide in the cytoplasmic membrane. eLife 2021, 10, e65836. [Google Scholar] [CrossRef]
- Yuan, X.; Lv, Z.Q.; Zhang, Z.Y.; Han, Y.; Liu, Z.Q.; Zhang, H.J. A review of antibiotics, antibiotic resistant bacteria, and resistance genes in aquaculture: Occurrence, contamination, and transmission. Toxics 2023, 11, 420. [Google Scholar] [CrossRef]
- Roulová, N.; Mot’ková, P.; Brozková, I.; Pejchalová, M. Antibiotic resistance of Pseudomonas aeruginosa isolated from hospital wastewater in the Czech Republic. J. Water Health 2022, 20, 692–701. [Google Scholar] [CrossRef]
- Shariati, A.; Azimi, T.; Ardebili, A.; Chirani, A.S.; Bahramian, A.; Pormohammad, A.; Sadredinamin, M.; Erfanimanesh, S.; Bostanghadiri, N.; Shams, S.; et al. Insertional inactivation of oprD in carbapenem-resistant Pseudomonas aeruginosa strains isolated from burn patients in Tehran, Iran. New Microb. New Infect. 2017, 20, 75–80. [Google Scholar] [CrossRef]
- Papanikolopoulou, A.; Gargalianos-Kakolyris, P.; Stoupis, A.; Moussas, N.; Pangalis, A.; Theodoridou, K.; Chronopoulou, G.; Pantazis, N.; Kantzanou, M.; Maltezou, H.C.; et al. Carbapenem-resistant Pseudomonas aeruginosa bacteremia, through a six-year infection control program in a hospital. Microorganisms 2023, 11, 1315. [Google Scholar] [CrossRef]

| Biochemical Project | Results | Biochemical Project | Results |
|---|---|---|---|
| Mannitol | − | Semi-solid agar (motility) | + |
| Hydrogen sulfide(H2S) | − | Glucose (gas) | − |
| Phenylalanine | − | Lysine | + |
| Glucose | + | Ornithine | + |
| Indole | − | Raffinose | − |
| Voges–Proskauer test | − | Sorbitol | − |
| Methyl red test | − | Urea | + |
| Citrate | + | Xylose | − |
| Antibiotics | Medication Dose (µg/tablet) | IZD (mm) | Sensitivity | Judgment Standard of Inhibition Zone Diameter (mm) | ||
|---|---|---|---|---|---|---|
| Resistant | Medium Sensitivity | Highly Sensitive | ||||
| Amikacin | 30 | 23 | S | ≤14 | 15–16 | ≥17 |
| Amoxicillin | 10 | 7 | I | ≤5 | 6–9 | ≥10 |
| Ampicillin | 10 | 7 | R | ≤13 | 14–16 | ≥17 |
| Azithromycin | 15 | 28 | S | ≤12 | – | ≥13 |
| Bacitracin | 0.04 | 7 | I | ≤6 | 7–9 | ≥10 |
| Cefadroxil | 30 | 7 | R | ≤13 | 14–16 | ≥17 |
| Cefazolin | 30 | 7 | R | ≤14 | 15–17 | ≥18 |
| Cefoperazone | 75 | 24 | S | ≤15 | 16–20 | ≥21 |
| Ceftazidime | 30 | 25 | S | ≤17 | 18–20 | ≥21 |
| Ceftriaxone | 30 | 28 | S | ≤13 | 14–22 | ≥23 |
| Ciprofloxacin | 5 | 35 | S | ≤15 | 16–20 | ≥21 |
| Cotrimoxazole | 23.75 | 11 | I | ≤10 | 11–15 | ≥16 |
| Erythromycin | 15 | 10 | R | ≤13 | 14–22 | ≥23 |
| Furazolidone | 300 | 7 | I | ≤5 | 6–9 | ≥10 |
| Gentamicin | 10 | 15 | S | ≤12 | 13–14 | ≥15 |
| Imipenem | 10 | 28 | S | ≤19 | 20–22 | ≥23 |
| Levofloxacin | 5 | 31 | S | ≤13 | 14–16 | ≥17 |
| Lincomycin | 2 | 7 | I | ≤5 | 6–11 | ≥12 |
| Meropenem | 10 | 31 | S | ≤19 | 20–22 | ≥23 |
| Norfloxacin | 10 | 28 | S | ≤12 | 13–16 | ≥17 |
| Ofloxacin | 5 | 22 | S | ≤12 | 13–15 | ≥16 |
| Polymyxin B | 300 | 14 | S | ≤8 | 9–11 | ≥12 |
| Rifampicin | 5 | 7 | I | ≤6 | 7–9 | ≥10 |
| Vancomycin | 30 | 7 | R | ≤9 | 10–11 | ≥12 |
Disclaimer/Publisher’s Note: The statements, opinions and data contained in all publications are solely those of the individual author(s) and contributor(s) and not of MDPI and/or the editor(s). MDPI and/or the editor(s) disclaim responsibility for any injury to people or property resulting from any ideas, methods, instructions or products referred to in the content. |
© 2025 by the authors. Licensee MDPI, Basel, Switzerland. This article is an open access article distributed under the terms and conditions of the Creative Commons Attribution (CC BY) license (https://creativecommons.org/licenses/by/4.0/).
Share and Cite
Li, H.; Qian, Z.; Yan, Y.; Wang, H. Isolation, Identification, and Drug Sensitivity Test of Pseudomonas aeruginosa from Cynomolgus Monkey (Macaca fascicularis). Vet. Sci. 2025, 12, 636. https://doi.org/10.3390/vetsci12070636
Li H, Qian Z, Yan Y, Wang H. Isolation, Identification, and Drug Sensitivity Test of Pseudomonas aeruginosa from Cynomolgus Monkey (Macaca fascicularis). Veterinary Sciences. 2025; 12(7):636. https://doi.org/10.3390/vetsci12070636
Chicago/Turabian StyleLi, Heling, Ziyao Qian, Yulin Yan, and Hong Wang. 2025. "Isolation, Identification, and Drug Sensitivity Test of Pseudomonas aeruginosa from Cynomolgus Monkey (Macaca fascicularis)" Veterinary Sciences 12, no. 7: 636. https://doi.org/10.3390/vetsci12070636
APA StyleLi, H., Qian, Z., Yan, Y., & Wang, H. (2025). Isolation, Identification, and Drug Sensitivity Test of Pseudomonas aeruginosa from Cynomolgus Monkey (Macaca fascicularis). Veterinary Sciences, 12(7), 636. https://doi.org/10.3390/vetsci12070636

